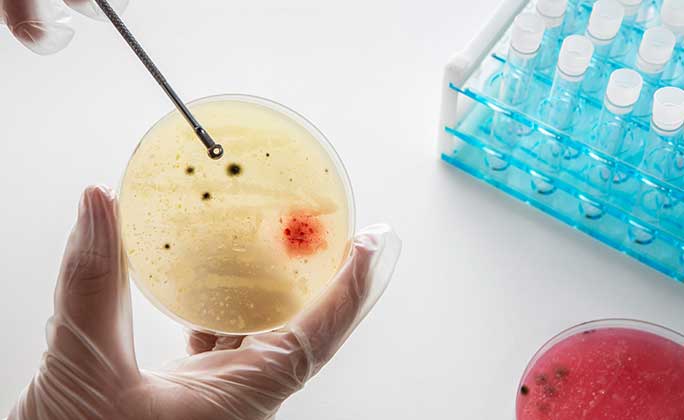
Microbiology and Immunology

Departments

Anatomy and Embryology
The Anatomy & Embryology Department focuses on human anatomy and embryology, emphasizing the structure and development of the human body. Students gain a deep understanding of anatomical relationships and developmental processes through practical dissections and laboratory work, essential for medical practice.
Staff Members

Medical Physiology
The Medical Physiology Department explores the functions of the various body systems, emphasizing homeostasis mechanisms through lectures and laboratory experiments to illustrate physiological principles in both health and disease.

Medical Biochemistry and Molecular biology
The Medical Biochemistry and Molecular Biology Department provides students with a deep understanding of the biochemical processes at the molecular level that underpin health and disease. Courses cover metabolism, genetic engineering techniques, and their applications in medicine, equipping students with knowledge essential for understanding and advancing healthcare.

Histology
The Histology Department focuses on the microscopic structures of tissues. Students learn tissue preparation techniques and study cellular organization, which are fundamental for understanding pathology and disease processes.

Pathology
The Anatomic Pathology Department trains students in studying disease processes through the examination of tissues. Training includes histopathological techniques, crucial for diagnosing diseases based on tissue samples, enabling students to understand the structural alterations associated with various diseases.

Clinical and Chemical Pathology
The Clinical and Chemical Pathology Department specializes in laboratory medicine, with a focus on analyzing blood and other bodily fluids to diagnose diseases. Students learn various diagnostic techniques, including hematology, microbiology, and biochemistry, gaining a deep understanding of the principles and practices of laboratory diagnosis.

Urological Surgery
The Urological Surgery Department specializes in the diagnosis and treatment of conditions affecting the urinary tract system and male reproductive organs. Students are trained in minimally invasive surgical techniques for managing conditions like kidney stones, prostate issues, and urinary tract infections.

Plastic Surgery
The Plastic Surgery Department trains students in reconstructive and aesthetic surgery, teaching them techniques for repairing defects or enhancing appearance. This includes procedures such as grafting, facial reconstruction, and cosmetic enhancements, providing students with the surgical skills to restore form and function or enhance cosmetic appearance.

Critical Care Medicine
The Critical Care Medicine Department equips students with the skills to manage critically ill patients requiring intensive monitoring and treatment. The curriculum covers respiratory support, hemodynamic monitoring, and advanced life support techniques, providing students with the expertise to handle complex and life-threatening medical situations within intensive care units.

Medical Pharmacology
The Medical Pharmacology Department educates students on drug mechanisms of action, therapeutic uses, side effects, interactions, and pharmacokinetics, providing the knowledge essential for safe medication practices and effective pharmacological interventions.
Microbiology and Immunology
The Medical Microbiology department studies microorganisms such as bacteria, viruses, and fungi that affect human health through cultivation techniques and laboratory analysis for the diagnosis of of infectious diseases.

Medical Parasitology
The Medical Parasitology department is dedicated to the study of parasites that impact human health. The curriculum covers their biology, life cycles, transmission routes, diagnosis methods, treatment options, and preventive measures against parasitic infections.

Family medicine
The Family Medicine Department emphasizes comprehensive healthcare for individuals of all ages. The curriculum covers preventive care strategies and chronic disease management within a family context, fostering holistic patient care approaches and addressing the diverse healthcare needs of individuals and families.

Community, Occupational, and Environmental Medicine
The Community, Occupational and Environmental Medicine Department focuses on public health issues related to community health promotion, occupational hazards, and environmental factors affecting health. Students gain expertise in preventive medicine strategies aimed at improving population health outcomes.

Anesthesia and Surgical Intensive Care
The Anesthesia and Surgical Intensive Care Department provides comprehensive training in anesthesia techniques for surgical procedures and critical care management for post-operative patients. Students learn about pain management, sedation protocols, and the monitoring of patients during surgery to ensure safety and efficacy.

Obstetrics and Gynecology
The Obstetrics and Gynecology Department specializes in women's health across the lifespan, encompassing pregnancy, childbirth, reproductive health, and gynecological disorders. Students receive training in prenatal care, labor management, and various gynecological procedures, including surgical interventions like cesarean sections.

Orthopedic Surgery
The Orthopedic Surgery Department focuses on the diagnosis and treatment of musculoskeletal injuries and disorders. Students learn surgical techniques for repairing bones, joints, ligaments, tendons, and muscles, with an emphasis on rehabilitation practices to restore function and mobility.

Vascular Surgery
The Vascular Surgery Department specializes in the management of diseases affecting blood vessels. Training encompasses both endovascular techniques and traditional surgical methods for treating conditions such as aneurysms and peripheral artery disease.

Forensic Medicine and Clinical Toxicology
The Forensic Medicine and Clinical Toxicology Department explores the intersection of medicine and law, providing expertise in forensic pathology, toxicology, and legal medicine. Students are trained in handling medico-legal cases, understanding the application of medical knowledge in legal proceedings.

Internal Medicine
The Internal Medicine Department offers comprehensive training in adult medicine, encompassing the prevention, diagnosis, and treatment of a wide spectrum of diseases. Students develop expertise in various subspecialties, including cardiology, endocrinology, and gastroenterology, gaining a broad understanding of internal medicine practices.

Pediatrics
The Pediatrics Department is dedicated to the health care of infants, children, and adolescents. It covers growth and development, pediatric diseases, preventive care, and child psychology. The curriculum prepares students to address the unique medical needs of younger populations effectively.

General Surgery
The General Surgery Department provides comprehensive training in surgical techniques for a variety of conditions. Students gain practical experience in surgical procedures through simulations and clinical rotations, developing expertise in managing conditions affecting the abdomen, breast, skin, and soft tissues.

Chest Medicine Department
The Chest Medicine Department is dedicated to the diagnosis and treatment of respiratory diseases. The department emphasizes both clinical practice and research, providing students with hands-on experience in managing patients with asthma, chronic obstructive pulmonary disease (COPD), T.B. pneumonia, and lung cancer.

Diagnostic and Interventional Radiology
The Diagnostic and Interventional Radiology Department utilizes imaging techniques for diagnosing and treating diseases. This includes X-rays, CT scans, MRIs, and ultrasound, as well as interventional radiology procedures like biopsies and catheter placements. Students gain expertise in interpreting imaging results and understanding the integral role of radiology in patient management.

Ophthalmology
The Ophthalmology Department provides students with comprehensive knowledge of eye diseases and vision disorders. They learn diagnostic techniques, including visual acuity tests and fundus examinations, and gain experience in surgical procedures such as cataract surgery, developing the expertise to diagnose, treat, and manage various ophthalmological conditions.

Neurology, and Psychiatry
The Neurology and Psychiatry Department provides specialized training in the study and treatment of neurological disorders and mental health issues. Students gain a comprehensive understanding of neuroanatomy, neurophysiology, psychiatric disorders, and therapeutic interventions to prepare them for careers in neurology and psychiatry.

Geriatrics Medicine
The Geriatrics Medicine Department focuses on the healthcare of elderly patients, addressing the unique challenges and needs of this population. The curriculum covers age-related diseases, geriatric syndromes like frailty or delirium, and comprehensive geriatric assessments, equipping students with the knowledge and skills to provide compassionate and effective care for older adults.

Dermatology, Venereology, and Andrology
The Dermatology, Venereology and Andrology Department specializes in skin diseases, sexually transmitted infections, and male reproductive health. Students receive training in diagnosing and treating a wide range of conditions, including eczema, psoriasis, acne, and STIs. They gain practical experience through clinical rotations and learn about the latest dermatological procedures and therapies.

Neurosurgery
The Neurosurgery Department is dedicated to surgical interventions for neurological disorders affecting the brain and spine. Students gain experience in managing complex procedures, including tumor excision, spinal surgeries, and trauma care, developing expertise in handling neurological emergencies.

Endemic Medicine
The Endemic Medicine Department specializes in diseases prevalent in specific geographic areas. Students delve into the study of conditions like malaria, schistosomiasis, and other tropical diseases, learning about epidemiology, prevention strategies, and treatment options for endemic conditions affecting local community.

Cardiology
The Cardiology Department is dedicated to the diagnosis and treatment of heart-related conditions. Students delve into cardiovascular physiology, diagnostic tests like echocardiograms, and management strategies for heart disease, gaining a comprehensive understanding of cardiovascular health and disease.

Rheumatology, Rehabilitation, and Physical Medicine
The Rheumatology, Rehabilitation & Physical Medicine Department focuses on the diagnosis and treatment of musculoskeletal disorders and rehabilitation techniques. Students learn physical therapy methods and pain management strategies for patients with chronic conditions, such as arthritis or post-surgical recovery, enhancing their expertise in restoring function and improving quality of life.

Clinical Oncology and Nuclear Medicine
The Clinical Oncology and Nuclear Medicine Department specializes in cancer diagnosis and treatment. Students learn about oncological principles, including chemotherapy, radiation therapy, and nuclear medicine techniques, and gain exposure to advanced imaging technologies used in cancer management.

Otorhinolaryngology
The Otorhinolaryngology Department focuses on disorders of the ear, nose, throat (ENT), and related structures of the head and neck. The discipline covers both medical management and surgical techniques for conditions like sinusitis, hearing loss, and throat cancers, providing students with a comprehensive understanding of ENT disorders and their management.

Cardiothoracic Surgery
The Cardiothoracic Surgery Department provides training in surgical techniques related to the heart and lungs, encompassing cardiac surgery for heart disease and thoracic surgery for lung conditions. Students learn both open-heart surgeries and minimally invasive approaches, developing expertise in complex surgical interventions involving the heart and lungs.

Pediatric Surgery Department
The Pediatric Surgery Department specializes in surgical interventions for infants and children with congenital or acquired conditions. Training encompasses the management of pediatric trauma cases as well as elective surgeries for conditions such as hernias or malformations. Students develop the specialized skills needed to perform surgery on younger patients effectively and safely.


